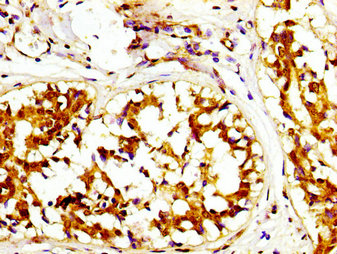
CSB-PA614529LA01HU

CAPRIN1
CAPRIN1,全稱為cell cycle associated protein 1,是一種細胞質磷酸蛋白,在神經元突觸可塑性和多種細胞類型的細胞增殖和遷移中發揮重要作用。該蛋白在腦部以外的組織中水平與細胞增殖密切相關。研究表明,抑制人類Caprin-1的表達會導致細胞增殖速率減慢,這表明其對于正常的細胞增殖至關重要。Caprin-1蛋白還與應激顆粒的形成有關,應激顆粒是真核細胞質中形成的細胞器,對各種應激源做出反應,如熱激和滲透壓變化。Caprin-1和USP10是應激顆粒的重要組成蛋白,它們通過結合G3BP1 NTF2L調節應激顆粒的形成,但具有相反的功能:Caprin-1促進應激顆粒的形成,而USP10抑制應激顆粒的形成。Caprin-1蛋白的相關疾病包括癌癥和一些神經退行性疾病。目前,針對Caprin-1蛋白的藥物研發正在進行中,例如東麗株式會社研發的人源化單克隆抗體TRK-950,正處于治療食道癌和胃癌的臨床二期研究階段。
熱銷產品
Recombinant Human Caprin-1 (CAPRIN1) (CSB-BP614529HU)
驗證數據

Based on the SEQUEST from database of Baculovirus host and target protein, the LC-MS/MS Analysis result of CSB-BP614529HU could indicate that this peptide derived from Baculovirus-expressed Homo sapiens (Human) CAPRIN1.

Based on the SEQUEST from database of Baculovirus host and target protein, the LC-MS/MS Analysis result of CSB-BP614529HU could indicate that this peptide derived from Baculovirus-expressed Homo sapiens (Human) CAPRIN1.

(Tris-Glycine gel) Discontinuous SDS-PAGE (reduced) with 5% enrichment gel and 15% separation gel.
CAPRIN1 Antibody (CSB-PA614529LA01HU)
驗證數據

IHC image of CSB-PA614529LA01HU diluted at 1:200 and staining in paraffin-embedded human small intestine tissue performed on a Leica BondTM system. After dewaxing and hydration, antigen retrieval was mediated by high pressure in a citrate buffer (pH 6.0). Section was blocked with 10% normal goat serum 30min at RT. Then primary antibody (1% BSA) was incubated at 4°C overnight. The primary is detected by a biotinylated secondary antibody and visualized using an HRP conjugated SP system.
IHC image of CSB-PA614529LA01HU diluted at 1:200 and staining in paraffin-embedded human breast cancer performed on a Leica BondTM system. After dewaxing and hydration, antigen retrieval was mediated by high pressure in a citrate buffer (pH 6.0). Section was blocked with 10% normal goat serum 30min at RT. Then primary antibody (1% BSA) was incubated at 4°C overnight. The primary is detected by a biotinylated secondary antibody and visualized using an HRP conjugated SP system.

Immunofluorescence staining of Hela cells with CSB-PA614529LA01HU at 1:66, counter-stained with DAPI. The cells were fixed in 4% formaldehyde, permeabilized using 0.2% Triton X-100 and blocked in 10% normal Goat Serum. The cells were then incubated with the antibody overnight at 4°C. The secondary antibody was Alexa Fluor 488-congugated AffiniPure Goat Anti-Rabbit IgG(H+L).
CAPRIN1 Antibodies
CAPRIN1 for Homo sapiens (Human)
| 產品貨號 | 產品名稱 | 種屬反應性 | 應用類型 |
|---|---|---|---|
| CSB-PA004505GA01HU | CAPRIN1 Antibody | Human,Mouse,Rat | ELISA,WB,IHC,IF |
| CSB-PA223919 | CAPRIN1 Antibody | Human,Mouse,Rat | ELISA,WB |
| CSB-PA288517 | CAPRIN1 Antibody | Human,Mouse,Rat | ELISA,WB |
| CSB-PA614529LA01HU | CAPRIN1 Antibody | Human | ELISA, IHC, IF |
CAPRIN1 Proteins
CAPRIN1 Proteins for Homo sapiens (Human)
| 產品貨號 | 產品名稱 | 來源 |
|---|---|---|
| CSB-YP614529HU1 CSB-EP614529HU1 CSB-BP614529HU1 CSB-MP614529HU1 CSB-EP614529HU1-B |
Recombinant Human Caprin-1 (CAPRIN1), partial | Yeast E.coli Baculovirus Mammalian cell In Vivo Biotinylation in E.coli |
| CSB-BP614529HU | Recombinant Human Caprin-1 (CAPRIN1) | Baculovirus |
| CSB-MP614529HU | Recombinant Human Caprin-1 (CAPRIN1) | Mammalian cell |













